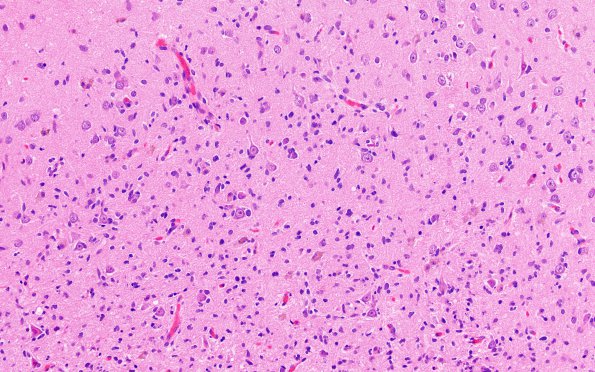
1A4 PLNTY (Case 1) A1 H&E 2

Table of Contents
Washington University Experience | NEOPLASMS (GLIAL) | PLNTY | 1A4 PLNTY (Case 1) A1 H&E 2
Tumor cells infiltrate the white and gray matter and occasionally abut the pial surface. Other areas of the tumor are composed of neoplastic cells which are oval with a more astrocytic appearance.